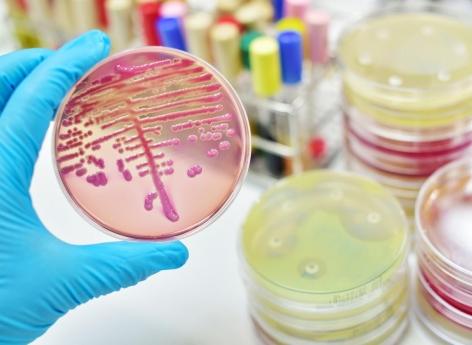

Infectiologie
Méningite : un cluster signalé à Strasbourg
L’Agence Régionale de Santé Grand-Est (ARS) alerte sur 4 cas d’infections invasives à méningocoque (IIM), dont un décès chez l'un des quatre jeunes qui avaient fréquenté les mêmes lieux festifs à Strasbourg.

- Gilnature/iStock
Les méningites à méningocoques sont rares en France mais elles peuvent tuer et ont fait une nouvelle victime. À Strasbourg, une personne est morte après avoir contracté cette pathologie dans une boîte de nuit.
La méningite se transmet lors d'un contact proche et prolongé
La victime faisait partie des quatre jeunes, âgés de 19 à 33 ans, qui avaient été diagnostiqués depuis le début du mois de novembre et qui avaient tous fréquenté des lieux festifs nocturnes (discothèques, bars…) de l’hyper centre-ville de Strasbourg, dont l’établissement le "LIVE CLUB". Les trois autres personnes ont suivi un traitement antibiotique et ne sont plus malades, a indiqué l’Agence Régionale de Santé Grand Est (ARS) dans un communiqué relayé par France 3 Grand Est.
Il existe plusieurs types de méningocoques, indique le ministère de la Santé et de la Prévention. "Les plus fréquents en France sont les méningocoques de groupe B, C, W et Y. Les méningocoques sont des bactéries normalement présentes dans la gorge et le nez de nombreuses personnes. Ces bactéries peuvent se transmettre par voie aérienne ou par la salive. Le méningocoque ne survit pas dans le milieu extérieur. Sa transmission est interhumaine et nécessite un contact proche (moins de 1 mètre) et prolongé”.
Quels sont les symptômes de la méningite ?
L’autorité sanitaire invite les personnes fréquentant régulièrement les lieux festifs de ce quartier depuis le 18 novembre à surveiller les symptômes évocateurs de la maladie : fièvre, céphalées, vomissements, raideur de la nuque et une ou plusieurs taches rouges ou violacées d’apparition rapide (purpura).
En cas de doute, il est recommandé d’appeler le 15 en urgence. L'Agence régionale de santé appelle les professionnels de santé à une "extrême vigilance si de nouveaux patients arrivent avec les mêmes symptômes", rapporte le service communication de l'ARS.